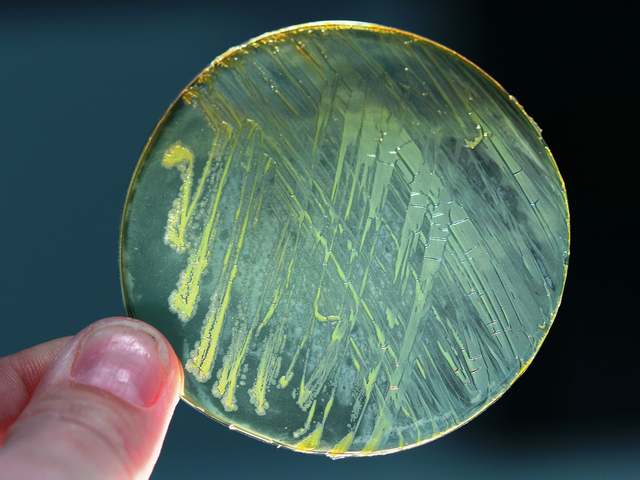

Бактерии-антидепрессанты в почве: как грязь делает нас счастливей?Фармакологические антидепрессанты и транквилизаторы далеко не единственный способ избавиться от серьезной депрессии. Было обнаружено, что микробы, содержащиеся в почве, оказывают схожий эффект на мозг человека без побочных отрицательных эффектов и какой-либо вероятности химической зависимости. Узнайте, как использовать естественный антидепрессант находящийся в почве и сделать себя счастливее и здоровее! Читайте дальше, чтобы узнать, как грязь сделает нас счастливее. ![]() Природные средства исцеляющие человека всегда присутствовали вокруг нас. Их использовали для лечения почти любого физического недуга, а также для избавления от психических и эмоциональных недугов. Древние лекари не могли знать, почему это работало, а просто применяли их. Современные ученые разгадали, почему многие лекарственных растения и труд на природе, улучшает качество жизни человека. Но лишь совсем недавно они нашли средства, которые ранее были неизвестны, и все же, до сих пор являются часть естественного жизненного цикла. Микробы в почвы и здоровье человека имеют тесную связь, которая была изучена и подтверждена. Почвенные микроорганизмы и здоровье человекаЗнаете ли вы, что существует естественный антидепрессант в почве? Это правда! "Mycobacterium vaccae" - живой компонент, который влияет на нейроны, как некоторые фармакологические препараты. Бактерия встречается в почве и стимулирует выработку серотонина, который расслабляет человека и делает его счастливее. Исследования, проводимые на больных раком, показали, что качество жизни пациентов улучшилось и они стали испытывать меньше стресса. ![]() Недостаток серотонина тесно связан с депрессией, тревогой, обсессивно-компульсивного расстройством и биполярными проблемами личности. Бактерии - естественные антидепрессанты в почве, которые не оказывают отрицательного воздействия на здоровье человека. Их легко получить, просто работая на земле. Большинство заядлых садоводов скажут вам, что их дачный участок является для них неким островком счастья, а физическая работа в саду снижает стресс и поднимает настроение. Тот факт, что в их словах есть некоторая закономерность, было подтверждено исследованиями проводимых на контрольной группой крыс. Присутствие антидепрессанта почвенных бактерий не является неожиданностью для многих из нас, кто уже испытал это явление на себе. Подкрепленная информация наукой является интересной, но не шокирующей, для многих дачников. ![]() Бактерии-антидепрессанты, содержащиеся в почве также исследовали на предмет улучшения когнитивных функций, влияния на болезнь Крона и даже лечения ревматоидного артрита. Они увеличивают уровень цитокина, что приводит к повышению уровня серотонина. Бактерии была введены испытуемым крысам с помощью инъекций, и результатом этого стало повышение их когнитивных способностей, более низкое напряжение и лучшая концентрация для решения задач, чем в другой контрольной группе крыс. Дачники постоянно вдыхают всё новые и новые порции бактерий, а через непосредственный контакт с кожей заносят их в кровоток, когда есть порезы или другие пути для инфекции. Эффект от природных антидепрессантов сохранялся в испытуемой группе крыс в течение 3 недель. Так кто же вам мешает улучшить своё настроение и жизнь? |